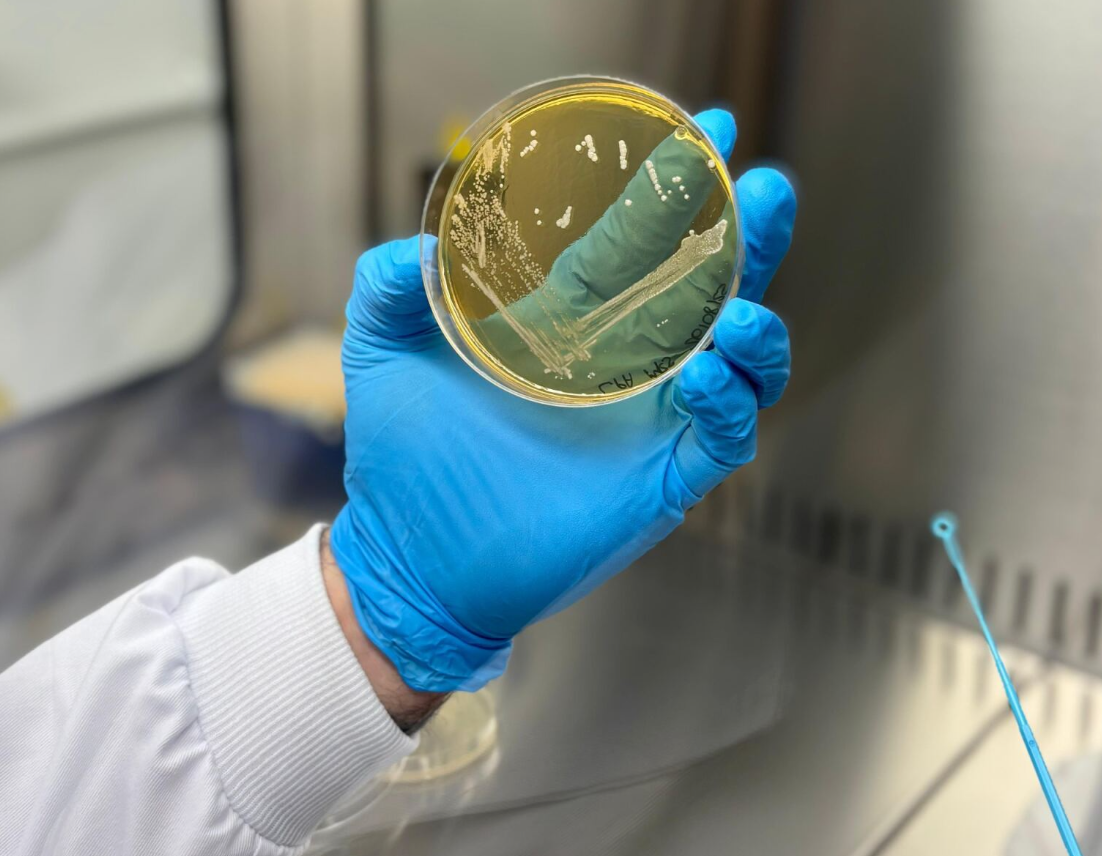

ROELMI HPC, azienda attiva nel settore degli ingredienti innovativi e sostenibili per il mercato cosmetico e nutraceutico, dà il via a una nuova fase del suo processo evolutivo, inaugurando la nuova legal entity ROELMI BIOTECH e il nuovo impianto produttivo a Gerenzano (Varese).
Dedicato alla bio-fermentazione di precisione e situato all’interno dell’Insubria BioPark (ottavo parco scientifico tecnologico e incubatore di imprese in Italia nel settore biotech), il nuovo stabilimento nasce con l’obiettivo di controllare e integrare la capacità produttiva, garantire standard qualitativi sempre più elevati e adottare tecnologie all’avanguardia nel rispetto dell’ambiente, così da portare il know-how dell’azienda nel campo delle biotecnologie bianche dal laboratorio a una scala di produzione industriale.
Un traguardo, questo, che affonda le sue radici in un percorso iniziato nel 2008, quando con l’azienda PRINCIPIUM B.S.I. viene sviluppato il metodo di fermentazione dedicato ai metaboliti dell’acido ialuronico che, l’anno successivo, si concretizza nella linea cosmetica PrincipHYAL®, realizzata con la tecnologia Full Spectrum Hyaluronans: un approccio capace di creare un ampio spettro di pesi molecolari in grado di lavorare in sinergia, ricreando ciò che naturalmente accade nella pelle e aprendo così nuove prospettive per il mondo beauty e personal care.
Questa visione si amplia ulteriormente nel 2010, quando le stesse basi tecnologiche vengono applicate all’ambito nutraceutico, dando vita alla linea ExceptionHYAL®, ingredienti per integratori alimentari progettati per sostenere il benessere.
La volontà di spingersi sempre oltre i propri limiti porta il gruppo a inaugurare a Novara, nel 2022, un laboratorio di ricerca e sviluppo interamente dedicato alla fermentazione e alla creazione di processi biotecnologici d’avanguardia, capaci di evolvere dal banco di laboratorio fino alla produzione su scala industriale.
Oggi, con la nascita di ROELMI BIOTECH, questo percorso si arricchisce di una nuova tappa: un polo di produzione e ricerca interamente focalizzato sulla fermentazione e sulla circular economy, trasformando sottoprodotti dell’industria agricola italiana in nuove risorse, migliorando l’efficienza produttiva di alcuni ingredienti di interesse, con l’obiettivo di ridurre l’impatto ambientale e contribuire non solo al benessere delle persone, ma anche del pianeta.
«L’apertura di questo impianto è per noi motivo di grande orgoglio – ha dichiarato Eleonora Santus, general manager di ROELMI BIOTECH –. Si tratta di un passo strategico che rafforza la nostra presenza sul mercato, valorizza il territorio e conferma il nostro impegno verso una produzione sostenibile e responsabile».